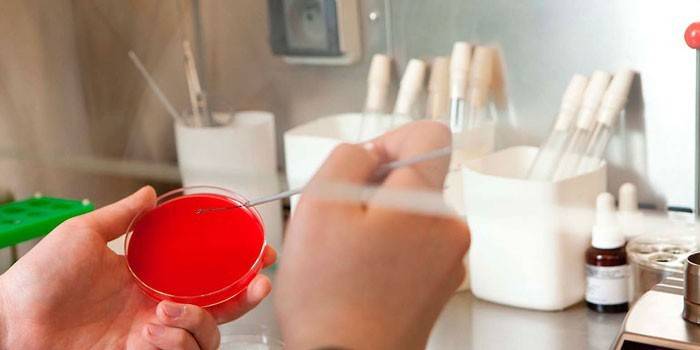

Hongo en los labios: síntomas y tratamiento de la enfermedad.
Si aparece una mermelada en la esquina de los labios, es posible que se desarrolle un hongo en los labios, que debe tratarse de manera oportuna. Esta enfermedad infecciosa es difícil de terapia conservadora, no puede prescindir del uso de medicamentos antimicóticos locales y sistémicos. Con este tipo de lesión, la placa blanca aparece primero en las comisuras de los labios, luego se forman llagas dolorosas, con picazón e inflamación. Antes de comenzar un tratamiento efectivo, debe consultar a un especialista de manera oportuna y someterse a un diagnóstico.
¿Qué es el hongo labial?
Esta enfermedad infecciosa a menudo progresa en el período otoño-invierno, cuando hay una hipotermia prolongada del cuerpo y una inmunidad debilitada. Exteriormente, el foco de la patología tiene la forma de una mermelada habitual, provocada por una mayor actividad de la levadura candida. Tales heridas dolorosas reducen el apetito, causan dolor y una sensación de ardor. La patología se desarrolla por igual en la infancia y la edad adulta, y es propensa a un curso crónico en el cuerpo. Para excluir la propagación de la infección, debe comenzar a tomar medicamentos antimicóticos de manera oportuna.
Síntomas
Antes de tomar las pruebas, el paciente nota cambios en la salud general, con lo cual debe comunicarse inmediatamente con el terapeuta local, luego con un especialista de perfil estrecho. De lo contrario, el tratamiento efectivo es complicado, notablemente retrasado, provocando complicaciones graves. Con este tipo de inflamación, es necesario concentrarse en los siguientes signos de una infección micótica en los labios:
- bordes claros del borde de los labios;
- incomodidad al pelar la piel;
- la aparición de sensaciones desagradables de opresión en los labios;
- picazón severa, hinchazón;
- hiperemia de la mucosa oral;
- enrojecimiento de la erupción cutánea;
- Inestabilidad emocional.
Placa blanca en las comisuras de los labios en adultos.
La estomatitis por candidiasis se acompaña de una capa blanca, que se extiende no solo a la membrana mucosa, sino también a las encías y los labios. Con la aparición de úlceras, el problema de salud solo empeora, mientras adquiere una forma crónica, propensa a una recaída. Usando cremas antimicóticas, puede eliminar no solo el atasco, sino también eliminar rápidamente los depósitos blancos y los signos de inflamación.

Razones para la aparición.
La candidiasis en los labios en adultos a menudo se localiza en las comisuras de la boca, provocada por un sistema inmunitario debilitado, cuando después de una infección extremadamente indeseable hay una rápida multiplicación de hongos patógenos, la penetración de microbios en la circulación sistémica. La candidiasis de los labios ocurre después de un tratamiento prolongado con antibióticos, es el resultado de lesiones y microtraumas en los labios. A continuación se presentan otros factores que provocan la actividad de la flora patógena:
- la presencia de malos hábitos;
- estacionalidad de la enfermedad;
- la presencia de patologías del sistema endocrino;
- desnutrición
- hipotermia prolongada del cuerpo;
- factor climático
- situaciones estresantes;
- violación de las reglas de higiene personal de la cavidad oral;
- desequilibrio hormonal;
- enfermedades sistémicas del cuerpo.
Tipos de enfermedades
La candidiasis en los labios es provocada por una mayor actividad de hongos patógenos del género Candida, la enfermedad debe tratarse sistémicamente. El primer paso es someterse a un examen completo para determinar la naturaleza y el tipo de patología característica. La clasificación del hongo se presenta a continuación:
- Pseudomembranoso. Aparecen granos blancos dentro de los labios, placa en la mucosa, acompañada de picazón y ardor. El paciente experimenta no solo molestias, sino también dolor en los labios.
- Atrófica aguda Hay problemas de sensibilidad, aumento de la sequedad y ardor. La lengua duele al moverse en la cavidad oral, y el paciente se pone nervioso, irritable.
- Hiperplásico En un paciente adulto, las sensaciones gustativas cambian, predomina un ataque agudo de dolor al masticar alimentos, mientras que hay un aumento de la inflamación de las membranas mucosas de la superficie interna de los labios y la boca, se forman placas pronunciadas.
- Atrófica crónica El paciente siente una sensación de ardor y boca seca, labios rojos, la saliva adquiere una consistencia viscosa. La candidiasis crónica se caracteriza por recaídas sistemáticas.
Complicaciones del hongo en los labios.
Si aparecen grietas en los labios, es posible que pronto los síntomas desagradables del hongo se recuerden a sí mismos. Si la enfermedad no se trata de manera oportuna, la infección patógena penetra en las capas profundas de la dermis, lo que exacerba el proceso patológico. En este cuadro clínico, el daño a los vasos sanguíneos ocurre con una exacerbación adicional del sangrado local. Es importante optar por ungüentos antimicóticos efectivos, de lo contrario, el diagnóstico crónico no se puede curar por completo.
Diagnósticos
Después de un examen visual de los focos de patología, el médico tratante puede hacer un diagnóstico presuntivo. Sin embargo, para confirmarlo, es necesario someterse a una serie de pruebas de laboratorio, sin limitarse a raspar la piel dañada por la presencia de un hongo patógeno. Las pruebas obligatorias en un hospital son las siguientes:
- examen microscópico;
- sembrando el hongo en un medio nutriente;
- análisis de sangre para bioquímica.
Tratamiento de hongos en los labios
Las fotos de focos de patología en los labios asustan con su apariencia, por lo que la mayoría de los pacientes con síntomas visibles del hongo contactan a tiempo con un dermatólogo, no retrasan los métodos oficiales y alternativos con el inicio de la terapia conservadora. Aquí hay valiosas recomendaciones de profesionales calificados:
- Se requiere excluir el uso de alimentos grasos, fritos, picantes y salados, adherirse estrictamente a una dieta terapéutica.
- Durante la ingesta de vitaminas, la inmunidad se fortalece notablemente, lo que acelera el proceso natural de regeneración de los tejidos lesionados en los labios.
- Es importante evitar la hipotermia prolongada del cuerpo, de lo contrario, la dinámica positiva en el cuerpo está completamente ausente.
- Los métodos de medicina oficial y alternativa deben acordarse primero con el médico, la automedicación superficial está completamente excluida.
Tratamiento de drogas
Es posible consumir un hongo patógeno de manera productiva por métodos conservadores, lo principal es someterse a un tratamiento completo, en lugar de detenerse en las primeras mejoras de salud. Los siguientes médicos recetan los siguientes medicamentos para varios grupos farmacológicos para infecciones fúngicas:
- fármacos antimicóticos: fluconazol, diflucano, itraconazol;
- antisépticos locales: Tantum Verde, Horacept, Fucortsin;
- inmunoestimulantes: polioxidonio, cicloferón;
- complejos multivitamínicos: AlfaVit, Pikovit.
Drogas sistémicas
Con un hongo patógeno, se requiere tomar tabletas que proporcionen un efecto sistémico en el cuerpo. La elección de los medicamentos es realizada exclusivamente por el médico tratante, la duración de los cuidados intensivos es de 2 a 3 semanas. Aquí hay medicamentos efectivos en una dirección dada con una breve descripción:
- Diflucan Las cápsulas de gelatina deben tomarse por vía oral sin masticar. La dosis diaria es de 1 tableta 2 veces al día durante 14 días. Hay contraindicaciones, los efectos secundarios no están excluidos.
- Ketoconazol El medicamento especificado agrava el trabajo del hígado y los riñones, por lo que tomarlo sin permiso está estrictamente contraindicado. Dosis diaria: 1 tableta dos veces al día durante 2 semanas por vía oral.
Terapia local
Con mayor frecuencia, los ungüentos, geles y soluciones con nistatina se usan externamente para mejorar el proceso de regeneración de tejidos, para exterminar la flora patógena y sus síntomas acompañantes. Tales agentes de tratamiento lubrican regularmente los focos de la patología, mientras que el riesgo de efectos secundarios para un organismo debilitado es mínimo. En este caso, estamos hablando de las siguientes posiciones farmacológicas, cuyas fotografías se pueden encontrar en los sitios web médicos de la World Wide Web:
- Anfotericina Este es un medicamento antimicótico en forma de ungüento que necesita lubricar las convulsiones por la mañana y por la noche durante 2 a 3 semanas. Además, se pueden usar tabletas con un efecto antifúngico sistémico.
- Canesten Esta es una crema curativa que actúa según el mismo principio. Se requiere lubricar las manifestaciones del hongo en los labios por la mañana y por la noche, detener el tratamiento hasta que los síntomas de alarma desaparezcan por completo.

Dieta
Los alimentos picantes, salados, picantes y ahumados deberán abandonarse por completo durante el período de tratamiento conservador del hongo. Esto se explica por el hecho de que para el desarrollo de la flora patógena, estas son condiciones favorables que conducen a su reproducción a gran escala, mayor actividad. Los alimentos deben ser magros, es conveniente reducir la cantidad de sal, especias, grasas vegetales y animales. Los métodos de cocción preferidos son hervir, guisar, cocinar al vapor. La siguiente es una lista de alimentos prohibidos para hongos:
- azucar
- cariño
- papas
- plátanos
- pan
- productos lácteos;
- dulces
Estos son los alimentos útiles para un hongo progresivo, que es importante para enriquecer la dieta habitual del paciente:
- verduras y frutas frescas;
- fibra vegetal
- verdes como antioxidantes naturales;
- carnes magras y pescado;
- soja
Métodos populares
Si un hongo patógeno solo ha aparecido en los labios, puede eliminarse con remedios caseros preparados en casa.A continuación se presentan recetas probadas en el tiempo que tienen efectos antimicóticos, regenerativos y antiinflamatorios. Entonces
- En una proporción de 1: 1, combine dos ingredientes previamente molidos: corteza de roble y hojas secas de caléndula. Vierte 2 cucharadas. l materias primas 400 ml de agua hirviendo, insista bajo una tapa cubierta. Enfriar, colar el caldo, usar para enjuagar la boca por la mañana y por la noche durante 1 a 2 semanas. Todavía puedes frotar la mermelada con jugo de celidonia, aceite de caléndula.
- Se requiere disolver en 1 cucharada. agua tibia 1 cucharadita. bicarbonato de sodio, después de lo cual mezclar bien la composición alcalina hasta la completa disolución de los cristales sólidos. Luego use la composición terminada para enjuagar la cavidad oral un número ilimitado de veces por día. El curso del tratamiento es de hasta 7-10 días.
Prevención
Con mayor frecuencia, el labio inferior sufre del hongo, pero esto no significa que la infección tenga una ubicación local. Se requiere un enfoque integrado para un problema de salud, y es mejor protegerse de infecciones extremadamente indeseables de manera oportuna. Para esto, es necesario cumplir con las siguientes medidas preventivas, especialmente durante el período de deficiencia vitamínica estacional, bajando la temperatura ambiente:
- No se recomienda lamerse los labios con el viento;
- es importante usar productos de higiene bucal personalizados;
- excluir el contacto de los labios con las manos sucias;
- evite besos con personas cuyos labios muestran signos de un hongo patógeno;
- fortalecer regularmente la inmunidad, especialmente en el período otoño-invierno;
- usar cosméticos en condiciones de viento;
- Visite regularmente el consultorio del dentista.
Foto del hongo en los labios.

Video
 Deshágase de los remedios caseros de hongos. Tratamiento de hongos con remedios caseros.
Deshágase de los remedios caseros de hongos. Tratamiento de hongos con remedios caseros.
